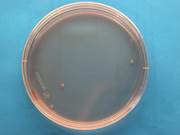

...Å oppdage små hull i nettene til merder i sanntid, er ikke en teknologi som er enkelt tilgjengelig i dagens marked. Inspeksjonsfirmaet Njord Aqua og SINTEF har utviklet en programvare som...

...Å oppdage små hull i nettene til merder i sanntid, er ikke en teknologi som er enkelt tilgjengelig i dagens marked. Inspeksjonsfirmaet Njord Aqua og SINTEF har utviklet en programvare som...

Nå kan alle interesserte laste ned data fra vår åpne skipsdesign og testplattform SINTEF Ocean Bulk Carrier (SOBC-1) for bruk i forskningsprosjekter og casestudier, for eksempel innen...

Liten og lur: Forsker og blogg-forfatter Runar Dahl-Hansen viser fram MEMS-brikken i SINTEFs mikro- og nanolab. Foto: William Husby Hoven Blogg Hørselstap er irreversibelt og den mest...

Det viser erfaringer fra flere klimaambisiøse prosjekter. Utslippsfrie prosjekter fører med seg mange utfordringer, Å holde fokus på utslipp samtidig som man utvikler løsninger...

Har du lyst til å være med og skape fremtidens energiløsninger? Nå har du sjansen til å utforske en forskerkarriere hos SINTEF, et av Europas ledende forskningsinstitutter....
Visuell historiefortelling Miniorganer gir håp om behandling av sykdommer Mange av sykdommene som det forskes på i miniorganene finnes det i dag ingen kur for. Av Idun Haugan og...

SINTEF legger frem rapporten "Teknologi for raskere global klimaomstilling” under årets klimatoppmøte COP29 i Aserbajdsjan. I forkant av årets klimatoppmøte har SINTEF utarbeidet...

...Å fange lusa før den setter seg på fisken kan forbedre fiskevelferden og redusere behandlingsindusert dødelighet. Nå skal SINTEF Ocean lede et prosjekt hvor det skal undersøkes...

Styrketrening gir økt muskelstyrke. For personer med Multippel sklerose (MS) eller Parkinsons sykdom kan intensiv styrketrening med høy belastning og få repetisjoner bremse symptomutviklingen...

Finansiering av klimaløsninger er et kjernepunkt under COP29. I dag finansierer det globale nord mye av arbeidet, siden land i vår del av verden oftere har bedre økonomiske...

Twin transition: Den nye boka belyser blant annet suksessfaktorene for digitalisering i ulike bransjer. Illustrasjon: SINTEF Manufacturing Kortnytt – Digitale teknologier og verktøy åpner...

Et urbant fordrøyende tak kan både være et attraktivt uteareal og et instrument for å håndtere overvannet. Men riktig prosjektering er avgjørende. Urbane fordrøyende...

For å oppnå vellykket implementering er utvikling, design og evaluering av CCS-verdikjeder som helhet nøkkelen. Mens utvikling og demonstrasjon av individuelle CO2-fangst-, transport-...

Politikk og retningslinjer som inkluderer naturbaserte løsninger og legger vekt på samarbeid, er viktig når vi skal skape mer klimarobuste samfunn. Lær mer i en ny podkast. Arktis...

Hvordan kommer denne havmiljøavtalen til å påvirke deg som er i det havbaserte næringslivet? Og hva har den med havrettstraktaten å gjøre? En traktat er noe som for noen...

Er du redd for at fri og ferie vil gjøre deg dummere i løpet av sommeren? Fortvil ikke, podkasten «Smart Forklart» gir deg fortløpende episoder med fakta du kan briljere med...

Det nye prosjektet INCA (Increased Capacity in the Cable Grid) skal bidra til mer effektiv drift av kraftnettet. INCA har fått 11,5 millioner i støtte under PILOT-E ordningen, som...

Et mindretall av norske kommuner vet om grunnskolene deres er universelt utformet. SINTEF-undersøkelsen viser også at uteområdene ofte overses. Illustrasjonsfoto: Shutterstock Standard...

Sol i laben: Martin Bellmann i SINTEF har lenge forsket på solceller. Nå koordinerer han prosjektet som skal gjøre det mulig å resirkulere materialene som brukes i panelene. Foto:...

...– 11. april kunngjorde Forskningsrådet en investering på 180 MNOK i et nytt forskningssenter for karbonfangst, -transport og -lagring (CCS) i Norge. gigaCCS er et forskningssenter for...